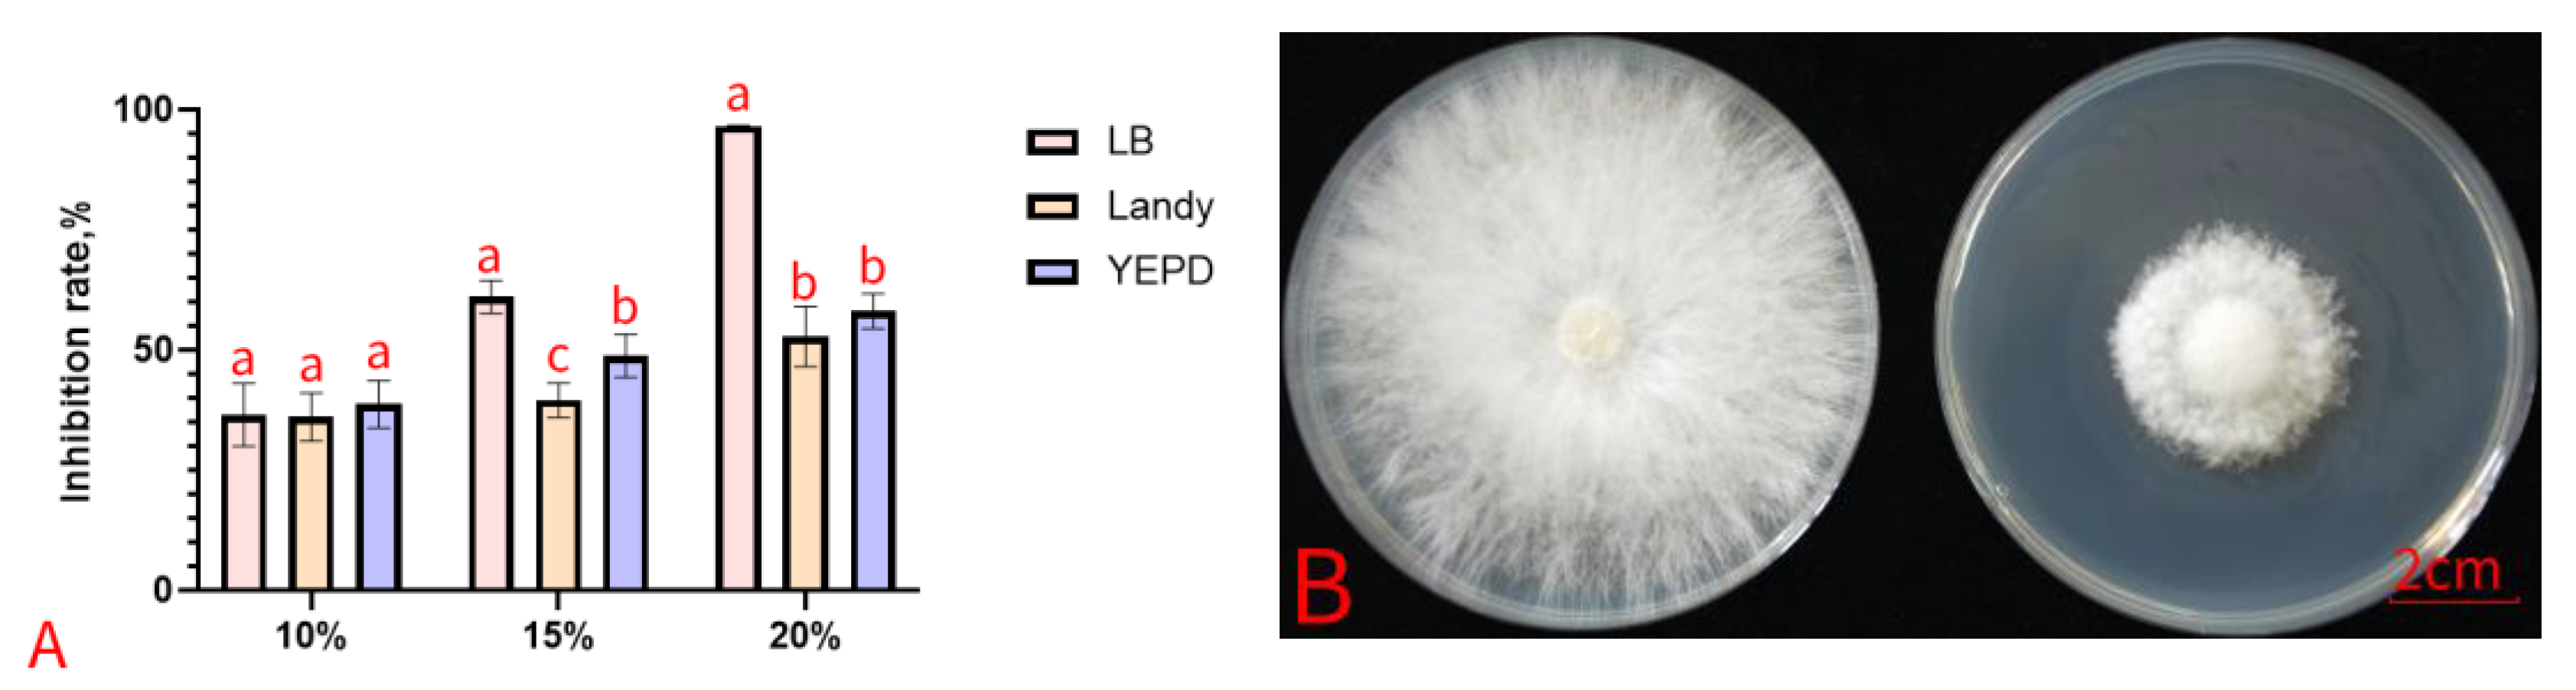
Agronomy 15 00568 g003

Peanut Growth Promotion and Biocontrol of Blight by Sclerotium rolfsii with Rhizosphere Bacterium, Bacillus siamensis YB-1632
Abstract
1. Introduction
2. Materials and Methods
2.1. Soil Sampling and Microbial Isolates
2.2. Screening Soil Bacteria for In Vitro Antifungal Activity
2.3. Biofilm Formation
2.4. Antifungal Activity of Bacterial Cell-Free Culture Filtrate
2.5. Antifungal Activity of Bacterial Volatiles
2.6. Biocontrol of PSB and Growth Promotion of Peanut by YB-1632
2.7. Identification of YB-1632
2.8. Putative Growth-Promoting and Biocontrol Factors of YB-1632
2.9. Peanut Enzymatic Activities and MDA Levels
2.10. Peanut Gene Expression
2.11. Statistical Analysis
3. Results
3.1. Screening and Identification of YB-1632
3.2. In Vitro Activities
3.3. In Planta Biocontrol and Plant Growth Promotion Activities
3.4. Plant Enzymatic Activities and MDA Content
3.5. Plant Gene Expression
4. Discussion
5. Conclusions
Supplementary Materials
Author Contributions
Funding
Data Availability Statement
Acknowledgments
Conflicts of Interest
References
- Zhao, L.; Zhu, X.; Yu, Y.; He, L.; Li, Y.; Zhang, L.; Liu, R. Comprehensive analysis of the anti-glycation effect of peanut skin extract. Food Chem. 2021, 362, 130169. [Google Scholar] [CrossRef] [PubMed]
- Hauser, A. Peanuts. J. Agric. Food Inf. 2018, 19, 195–202. [Google Scholar] [CrossRef]
- Kokalis-Burelle, N.; Porter, D.; Rodriguez-Kabana, R.; Smith, D. Subrahmanyam, Compendium of Peanut Diseases; American Phytopathological Society: Saint Paul, MN, USA, 1997. [Google Scholar]
- Liu, D.; Mao, X.; Zhang, G.; He, L.; Wang, L.; Zhang, F.; Wang, Q.; Zhou, L. Antifungal Activity and Mechanism of Physcion against Sclerotium rolfsii, the Causal Agent of Peanut Southern Blight. J. Agric. Food Chem. 2024, 72, 15601–15612. [Google Scholar] [CrossRef] [PubMed]
- Thiessen, L.D.; Woodward, J.E. Diseases of peanut caused by soilborne pathogens in the Southwestern United States. Int. Sch. Res. Not. 2012, 2012, 517905. [Google Scholar] [CrossRef]
- Han, Z.; Cui, K.; Wang, M.; Jiang, C.; Zhao, T.; Wang, M.; Du, P.; He, L.; Zhou, L. Bioactivity of the DMI fungicide mefentrifluconazole against Sclerotium rolfsii, the causal agent of peanut southern blight. Pest Manag. Sci. 2023, 79, 2126–2134. [Google Scholar] [CrossRef]
- Li, L.; Wang, J.; Liu, D.; Li, L.; Zhen, J.; Lei, G.; Wang, B.; Yang, W. The antagonistic potential of peanut endophytic bacteria against Sclerotium rolfsii causing stem rot. Braz. J. Microbiol. 2023, 54, 361–370. [Google Scholar] [CrossRef]
- Jia, S.; Song, C.; Dong, H.; Yang, X.; Li, X.; Ji, M.; Chu, J. Evaluation of efficacy and mechanism of Bacillus velezensis CB13 for controlling peanut stem rot caused by Sclerotium rolfsii. Front. Microbiol. 2023, 14, 1111965. [Google Scholar] [CrossRef]
- Coley-Smith, J.; Mitchell, C.M.; Sansford, C.E. Long-term survival of sclerotia of Sclerotium cepivorum and Stromatinia gladioli. Plant Pathol. 1990, 39, 58–69. [Google Scholar] [CrossRef]
- Haveri, N. Studies on Diversity of Scilerotium rolfsii Sacc. and Induced Systemic Resistance in Groundnut (Arachis hypogaea L.) Against Stem Rot Pathogen; Professor Jayashankar Telangana State Agricultural University: Rajendranagar, India, 2017. [Google Scholar]
- Yan, L.; Wang, Z.; Song, W.; Fan, P.; Kang, Y.; Lei, Y.; Wan, L.; Huai, D.; Chen, Y.; Wang, X.; et al. Genome sequencing and comparative genomic analysis of highly and weakly aggressive strains of Sclerotium rolfsii, the causal agent of peanut stem rot. BMC Genom. 2021, 22, 276. [Google Scholar] [CrossRef]
- Koehler, A.M.; Shew, H.D. Enhanced Overwintering Survival of Stevia by QoI Fungicides Used for Management of Sclerotium rolfsii. Plant Dis. 2017, 101, 1417–1421. [Google Scholar] [CrossRef]
- Gorbet, D.; Kucharek, T.; Shokes, F.; Brenneman, T. Field evaluations of peanut germplasm for resistance to stem rot caused by Sclerotium rolfsii. Peanut Sci. 2004, 31, 91–95. [Google Scholar] [CrossRef]
- Ganesan, P.; Gnanamanickam, S. Biological control of Sclerotium rolfsii Sacc. in peanut by inoculation with Pseudomonas fluorescens. Soil Biol. Biochem. 1987, 19, 35–38. [Google Scholar] [CrossRef]
- Jacob, S.; Sajjalaguddam, R.R.; Sudini, H.K. Streptomyces sp. RP1A-12 mediated control of peanut stem rot caused by Sclerotium rolfsii. J. Integr. Agric. 2018, 17, 892–900. [Google Scholar] [CrossRef]
- Xu, M.; Zhang, X.; Yu, J.; Guo, Z.; Wu, J.; Li, X.; Chi, Y.; Wan, S. Biological control of peanut southern blight (Sclerotium rolfsii) by the strain Bacillus pumilus LX11. Biocontrol Sci. Technol. 2020, 30, 485–489. [Google Scholar] [CrossRef]
- Abd-Allah, E. Effect of a Bacillus subtilis isolate on southern blight (Sclerotium rolfsii) and lipid composition of peanut seeds. Phytoparasitica 2005, 33, 460–466. [Google Scholar] [CrossRef]
- He, H.; Zhai, Q.; Tang, Y.; Gu, X.; Pan, H.; Zhang, H. Effective biocontrol of soybean root rot by a novel bacterial strain Bacillus siamensis HT1. Physiol. Mol. Plant Pathol. 2023, 125, 101984. [Google Scholar] [CrossRef]
- Yang, Y.; Zhang, Y.; Zhang, L.; Zhou, Z.; Zhang, J.; Yang, J.; Gao, X.; Chen, R.; Huang, Z.; Xu, Z. Isolation of Bacillus siamensis B-612, a strain that is resistant to rice blast disease and an investigation of the mechanisms responsible for suppressing rice blast fungus. Int. J. Mol. Sci. 2023, 24, 8513. [Google Scholar] [CrossRef]
- Gorai, P.S.; Ghosh, R.; Mandal, S.; Ghosh, S.; Chatterjee, S.; Gond, S.K.; Mandal, N.C. Bacillus siamensis CNE6-a multifaceted plant growth promoting endophyte of Cicer arietinum L. having broad spectrum antifungal activities and host colonizing potential. Microbiol. Res. 2021, 252, 126859. [Google Scholar] [CrossRef]
- Dong, Q.; Liu, Q.; Goodwin, P.H.; Deng, X.; Xu, W.; Xia, M.; Zhang, J.; Sun, R.; Wu, C.; Wang, Q.; et al. Isolation and Genome-Based Characterization of Biocontrol Potential of Bacillus siamensis YB-1631 against Wheat Crown Rot Caused by Fusarium pseudograminearum. J. Fungi 2023, 9, 547. [Google Scholar] [CrossRef]
- Shen, N.; Li, S.; Li, S.; Zhang, H.; Jiang, M. The siderophore-producing bacterium, Bacillus siamensis Gxun-6, has an antifungal activity against Fusarium oxysporum and promotes the growth of banana. Egypt. J. Biol. Pest Control 2022, 32, 34. [Google Scholar] [CrossRef]
- Li, Q.-S.; WU, L.-K.; Jun, C.; Khan, M.A.; Luo, X.-M.; Lin, W.-X. Biochemical and microbial properties of rhizospheres under maize/peanut intercropping. J. Integr. Agric. 2016, 15, 101–110. [Google Scholar] [CrossRef]
- Xu, W.; Yang, Q.; Xie, X.; Goodwin, P.H.; Deng, X.; Zhang, J.; Sun, R.; Wang, Q.; Xia, M.; Wu, C. Genomic and phenotypic insights into the potential of Bacillus subtilis YB-15 isolated from rhizosphere to biocontrol against crown rot and promote growth of wheat. Biology 2022, 11, 778. [Google Scholar] [CrossRef] [PubMed]
- Dong, Q.; Chang, Y.; Goodwin, P.H.; Liu, Q.; Xu, W.; Xia, M.; Zhang, J.; Sun, R.; Xu, S.; Wu, C.; et al. Double-Wing Motif Protein is a Novel Biofilm Regulatory Factor of the Plant Disease Biocontrol Agent, Bacillus subtilis. J. Agric. Food Chem. 2024, 72, 20273–20285. [Google Scholar] [CrossRef] [PubMed]
- Wang, W.Y.; Kong, W.L.; Liao, Y.C.; Zhu, L.H. Identification of Bacillus velezensis SBB and Its Antifungal Effects against Verticillium dahliae. J. Fungi 2022, 8, 1021. [Google Scholar] [CrossRef]
- Zhang, D.; Yu, S.; Yang, Y.; Zhang, J.; Zhao, D.; Pan, Y.; Fan, S.; Yang, Z.; Zhu, J. Antifungal Effects of Volatiles Produced by Bacillus subtilis Against Alternaria solani in Potato. Front. Microbiol. 2020, 11, 1196. [Google Scholar] [CrossRef]
- Li, X.; Chen, D.; Carrión, V.J.; Revillini, D.; Yin, S.; Dong, Y.; Zhang, T.; Wang, X.; Delgado-Baquerizo, M. Acidification suppresses the natural capacity of soil microbiome to fight pathogenic Fusarium infections. Nat. Commun. 2023, 14, 5090. [Google Scholar] [CrossRef]
- Ferdous, R.; Sultana, N.; Hossain, M.B.; Sultana, R.A.; Hoque, S. Exploring the potential human pathogenic bacteria in selected ready-to-eat leafy greens sold in Dhaka City, Bangladesh: Estimation of bacterial load and incidence. Food Sci. Nutr. 2024, 12, 1105–1118. [Google Scholar] [CrossRef]
- Saitou, N.; Nei, M. The neighbor-joining method: A new method for Trees, Reconstructing Phylogenetic. Mol. Biol. Evol. 1987, 4, 406–425. [Google Scholar]
- Chen, Q.; Liu, S. Identification and Characterization of the Phosphate-Solubilizing Bacterium Pantoea sp. S32 in Reclamation Soil in Shanxi, China. Front. Microbiol. 2019, 10, 2171. [Google Scholar] [CrossRef]
- Kazanas, N. Proteolytic activity of microorganisms isolated from freshwater fish. Appl. Microbiol. 1968, 16, 128–132. [Google Scholar] [CrossRef]
- Alqahtani, Y.S.; More, S.S.; Shaikh, I.A.; KJ, A.; More, V.S.; Niyonzima, F.N.; Muddapur, U.M.; Khan, A.A. Production and purification of pectinase from Bacillus subtilis 15A-B92 and its biotechnological applications. Molecules 2022, 27, 4195. [Google Scholar] [CrossRef] [PubMed]
- Schwyn, B.; Neilands, J.B. Universal chemical assay for the detection and determination of siderophores. Anal. Biochem. 1987, 160, 47–56. [Google Scholar] [CrossRef] [PubMed]
- Teather, R.M.; Wood, P.J. Use of Congo red-polysaccharide interactions in enumeration and characterization of cellulolytic bacteria from the bovine rumen. Appl. Environ. Microbiol. 1982, 43, 777–780. [Google Scholar] [CrossRef] [PubMed]
- Al-Naamani, L.S.; Dobretsov, S.; Al-Sabahi, J.; Soussi, B. Identification and characterization of two amylase producing bacteria Cellulosimicrobium sp. and Demequina sp. isolated from marine organisms. J. Agric. Mar. Sci. 2015, 20, 8–15. [Google Scholar] [CrossRef]
- Dhouib, H.; Zouari, I.; Abdallah, D.B.; Belbahri, L.; Taktak, W.; Triki, M.A.; Tounsi, S. Potential of a novel endophytic Bacillus velezensis in tomato growth promotion and protection against Verticillium wilt disease. Biol. Control 2019, 139, 104092. [Google Scholar] [CrossRef]
- Jogi, A.; Kerry, J.W.; Brenneman, T.B.; Leebens-Mack, J.H.; Gold, S.E. Identification of genes differentially expressed during early interactions between the stem rot fungus (Sclerotium rolfsii) and peanut (Arachis hypogaea) cultivars with increasing disease resistance levels. Microbiol. Res. 2016, 184, 1–12. [Google Scholar] [CrossRef]
- Awan, S.A.; Ilyas, N.; Khan, I.; Raza, M.A.; Rehman, A.U.; Rizwan, M.; Rastogi, A.; Tariq, R.; Brestic, M. Bacillus siamensis Reduces Cadmium Accumulation and Improves Growth and Antioxidant Defense System in Two Wheat (Triticum aestivum L.) Varieties. Plants 2020, 9, 878. [Google Scholar] [CrossRef]
- Sharma, A.; Kaushik, N.; Sharma, A.; Djébali, N. Development of novel liquid formulation of Bacillus siamensis with antifungal and plant growth promoting activity. ACS Agric. Sci. Technol. 2022, 3, 55–66. [Google Scholar] [CrossRef]
- You, W.; Ge, C.; Jiang, Z.; Chen, M.; Li, W.; Shao, Y. Screening of a broad-spectrum antagonist-Bacillus siamensis, and its possible mechanisms to control postharvest disease in tropical fruits. Biol. Control 2021, 157, 104584. [Google Scholar] [CrossRef]
- Hieu, N.X.; Huy, N.D.; Nguyen, T.L.; Thuyet, C.T.; Hoai, P.T.T.; Thuy, N.T.T. Controlling Soil-Borne Fungus Aspergillus niger in Groundnut By Optimizing The Function of Isolated Bacillus Bacteria. Malays. Appl. Biol. 2024, 53, 134–144. [Google Scholar] [CrossRef]
- Liang, Q.; Tan, D.; Chen, H.; Guo, X.; Afzal, M.; Wang, X.; Tan, Z.; Peng, G. Endophyte-mediated enhancement of salt resistance in Arachis hypogaea L. by regulation of osmotic stress and plant defense-related genes. Front. Microbiol. 2024, 15, 1383545. [Google Scholar] [CrossRef] [PubMed]
- Meng, J.; Zhang, X.; Han, X.; Fan, B. Application and Development of Biocontrol Agents in China. Pathogens 2022, 11, 1120. [Google Scholar] [CrossRef] [PubMed]
- Zhao, H.; Shao, D.; Jiang, C.; Shi, J.; Li, Q.; Huang, Q.; Rajoka, M.S.R.; Yang, H.; Jin, M. Biological activity of lipopeptides from Bacillus. Appl. Microbiol. Biotechnol. 2017, 101, 5951–5960. [Google Scholar] [CrossRef] [PubMed]
- Dewi, R.T.K.; Mubarik, N.R.; Suhartono, M.T. Medium optimization of β-glucanase production by Bacillus subtilis SAHA 32.6 used as biological control of oil palm pathogen. Emir. J. Food Agric. 2016, 28, 116–125. [Google Scholar] [CrossRef]
- Kumari, S.; Khanna, V.; Singh, A. Characterization and evaluation of extracellular hydrolytic proteins from rhizobacterial antagonists isolated from Fusarium oxysporum f. sp. ciceris infected chickpea fields. Indian Phytopathol. 2022, 75, 165–177. [Google Scholar] [CrossRef]
- Zhou, M.; Li, P.; Wu, S.; Zhao, P.; Gao, H. Bacillus subtilis CF-3 Volatile Organic Compounds Inhibit Monilinia fructicola Growth in Peach Fruit. Front. Microbiol. 2019, 10, 1804. [Google Scholar] [CrossRef]
- Wang, D.; Li, Y.; Yuan, Y.; Chu, D.; Cao, J.; Sun, G.; Ai, Y.; Cui, Z.; Zhang, Y.; Wang, F. Identification of non-volatile and volatile organic compounds produced by Bacillus siamensis LZ88 and their antifungal activity against Alternaria alternata. Biol. Control 2022, 169, 104901. [Google Scholar] [CrossRef]
- Limoli, D.H.; Jones, C.J.; Wozniak, D.J. Bacterial extracellular polysaccharides in biofilm formation and function. Microb. Biofilms 2015, 223–247. [Google Scholar] [CrossRef]
- Pandin, C.; Le Coq, D.; Canette, A.; Aymerich, S.; Briandet, R. Should the biofilm mode of life be taken into consideration for microbial biocontrol agents? Microb. Biotechnol. 2017, 10, 719–734. [Google Scholar] [CrossRef]
- Seneviratne, G.; Weerasekara, M.; Seneviratne, K.; Zavahir, J.; Kecskés, M.; Kennedy, I. Importance of biofilm formation in plant growth promoting rhizobacterial action. In Plant Growth and Health Promoting Bacteria; Springer: Berlin/Heidelberg, Germany, 2011; pp. 81–95. [Google Scholar]
- Yu, L.; Li, Q.; Zhu, Y.; Afzal, M.S.; Li, L. An auxin-induced β-type endo-1, 4-β-glucanase in poplar is involved in cell expansion and lateral root formation. Planta 2018, 247, 1149–1161. [Google Scholar] [CrossRef]
- Sharma, P.; Gayen, D. Plant protease as regulator and signaling molecule for enhancing environmental stress-tolerance. Plant Cell Rep. 2021, 40, 2081–2095. [Google Scholar] [CrossRef] [PubMed]
- Guleria, S.; Walia, A.; Chauhan, A.; Shirkot, C. Molecular characterization of alkaline protease of Bacillus amyloliquefaciens SP1 involved in biocontrol of Fusarium oxysporum. Int. J. Food Microbiol. 2016, 232, 134–143. [Google Scholar] [CrossRef] [PubMed]
- Li, Y.-J.; Hu, Q.-P. Studying of the promotion mechanism of Bacillus subtilis QM3 on wheat seed germination based on β-amylase. Open Life Sci. 2020, 15, 553–560. [Google Scholar] [CrossRef] [PubMed]
- Sayyed, R.; Chincholkar, S.; Reddy, M.; Gangurde, N.; Patel, P. Siderophore producing PGPR for crop nutrition and phytopathogen suppression. In Bacteria in Agrobiology: Disease Management; Springer: Berlin/Heidelberg, Germany, 2012; pp. 449–471. [Google Scholar]
- Mies, K.A.; Gebhardt, P.; Möllmann, U.; Crumbliss, A.L. Synthesis, siderophore activity and iron (III) chelation chemistry of a novel mono-hydroxamate, bis-catecholate siderophore mimic: Nα,-Nε-Bis [2, 3-dihydroxybenzoyl]-l-lysyl-(γ-N-methyl-N-hydroxyamido)-l-glutamic acid. J. Inorg. Biochem. 2008, 102, 850–861. [Google Scholar] [CrossRef] [PubMed]
- Ahmed, E.; Holmström, S.J. Siderophores in environmental research: Roles and applications. Microb. Biotechnol. 2014, 7, 196–208. [Google Scholar] [CrossRef]
- Partridge, D.; Sutton, T.; Jordan, D.; Curtis, V.; Bailey, J. Management of Sclerotinia blight of peanut with the biological control agent Coniothyrium minitans. Plant Dis. 2006, 90, 957–963. [Google Scholar] [CrossRef]
- Chen, L.; Wu, Y.; Chong, X.; Xin, Q.; Wang, D.; Bian, K. Seed-borne endophytic Bacillus velezensis LHSB1 mediate the biocontrol of peanut stem rot caused by Sclerotium rolfsii. J. Appl. Microbiol. 2020, 128, 803–813. [Google Scholar] [CrossRef]
- Carmo de Carvalho e Martins, M.d.; Martins; da Silva Santos Oliveira, A.S.; da Silva, L.A.A.; Primo, M.G.S.; de Carvalho Lira, V.B. Biological indicators of oxidative stress [malondialdehyde, catalase, glutathione peroxidase, and superoxide dismutase] and their application in nutrition. In Biomarkers in Nutrition; Springer: Berlin/Heidelberg, Germany, 2022; pp. 1–25. [Google Scholar]
- Silva, J.P.; Coutinho, O.P. Free radicals in the regulation of damage and cell death—Basic mechanisms and prevention. Drug Discov. Ther. 2010, 4, 144. [Google Scholar]
- Viswanath, K.K.; Varakumar, P.; Pamuru, R.R.; Basha, S.J.; Mehta, S.; Rao, A.D. Plant lipoxygenases and their role in plant physiology. J. Plant Biol. 2020, 63, 83–95. [Google Scholar] [CrossRef]
- Li, Y.; Zhang, S.; Jiang, W.; Liu, D. Cadmium accumulation, activities of antioxidant enzymes, and malondialdehyde (MDA) content in Pistia stratiotes L. Environ. Sci. Pollut. Res. Int. 2013, 20, 1117–1123. [Google Scholar] [CrossRef]
- Meena, M.; Zehra, A.; Dubey, M.K.; Aamir, M.; Gupta, V.K.; Upadhyay, R.S. Comparative evaluation of biochemical changes in tomato (Lycopersicon esculentum Mill.) infected by Alternaria alternata and its toxic metabolites (TeA, AOH, and AME). Front. Plant Sci. 2016, 7, 1408. [Google Scholar] [CrossRef] [PubMed]
- Choudhary, D.K.; Johri, B.N. Interactions of Bacillus spp. and plants–with special reference to induced systemic resistance (ISR). Microbiol. Res. 2009, 164, 493–513. [Google Scholar] [CrossRef] [PubMed]
- Choudhary, D.K.; Prakash, A.; Johri, B. Induced systemic resistance (ISR) in plants: Mechanism of action. Indian J. Microbiol. 2007, 47, 289–297. [Google Scholar] [CrossRef] [PubMed]
- Graham, J.; Colburn, G.; Chung, K.-R.; Cubero, J. Protection of citrus roots against infection by Phytophthora spp. by hypovirulent P. nicotianae is not related to induction of systemic acquired resistance. Plant Soil 2012, 358, 39–49. [Google Scholar] [CrossRef]
- Brunner, F.; Stintzi, A.; Fritig, B.; Legrand, M. Substrate specificities of tobacco chitinases. Plant J. 1998, 14, 225–234. [Google Scholar] [CrossRef]
- Federici, L.; Di Matteo, A.; Fernandez-Recio, J.; Tsernoglou, D.; Cervone, F. Polygalacturonase inhibiting proteins: Players in plant innate immunity? Trends Plant Sci. 2006, 11, 65–70. [Google Scholar] [CrossRef]
- Gullner, G.; Komives, T.; Király, L.; Schröder, P. Glutathione S-transferase enzymes in plant-pathogen interactions. Front. Plant Sci. 2018, 9, 1836. [Google Scholar] [CrossRef]
- Fernandes, H.; Michalska, K.; Sikorski, M.; Jaskolski, M. Structural and functional aspects of PR-10 proteins. FEBS J. 2013, 280, 1169–1199. [Google Scholar] [CrossRef]
- Borriss, R. Use of plant-associated Bacillus strains as biofertilizers and biocontrol agents in agriculture. In Bacteria in Agrobiology: Plant Growth Responses; Springer: Berlin/Heidelberg, Germany, 2011; pp. 41–76. [Google Scholar]
- Fira, D.; Dimkić, I.; Berić, T.; Lozo, J.; Stanković, S. Biological control of plant pathogens by Bacillus species. J. Biotechnol. 2018, 285, 44–55. [Google Scholar] [CrossRef]
- Miljaković, D.; Marinković, J.; Balešević-Tubić, S. The significance of Bacillus spp. in disease suppression and growth promotion of field and vegetable crops. Microorganisms 2020, 8, 1037. [Google Scholar] [CrossRef]
- Podile, A.R.; Kishore, G.K. Biological control of peanut diseases. In Biological Control of Crop Diseases; CRC Press: Boca Raton, FL, USA, 2002; pp. 145–174. [Google Scholar]
- Teixidó, N.; Usall, J.; Torres, R. Insight into a successful development of biocontrol agents: Production, formulation, packaging, and shelf life as key aspects. Horticulturae 2022, 8, 305. [Google Scholar] [CrossRef]

| Bacterial Isolate | Width (mm) | Bacterial Isolate | Width (mm) |
|---|---|---|---|
| ZY-15 | 1.13 ± 0.13 q | ZY-22 | 2.70 ± 0.20 i |
| ZY-14 | 1.21 ± 0.15 q | ZY-27 | 2.73 ± 0.15 i |
| ZY-25 | 1.23 ± 0.23 pq | ZY-9 | 2.77 ± 0.21 i |
| ZY-8 | 1.32 ± 0.22 opq | ZY-1 | 3.23 ± 0.15 h |
| ZY-5 | 1.38 ± 0.25 nopq | ZY-4 | 3.24 ± 0.24 h |
| ZY-28 | 1.57 ± 0.15 mnop | ZY-20 | 3.27 ± 0.21 h |
| ZY-3 | 1.58 ± 0.26 mno | ZY-21 | 3.57 ± 0.15 gh |
| ZY-34 | 1.63 ± 0.06 mno | ZY-29 | 3.77 ± 0.06 g |
| ZY-16 | 1.70 ± 0.18 mn | ZY-24 | 3.87 ± 0.15 g |
| ZY-26 | 1.73 ± 0.15 lm | ZY-11 | 4.18 ± 0.19 f |
| ZY-33 | 2.03 ± 0.15 kl | ZY-2 | 4.24 ± 0.25 f |
| ZY-31 | 2.07 ± 0.21 k | ZY-18 | 4.30 ± 0.10 ef |
| ZY-12 | 2.12 ± 0.24 k | ZY-17 | 4.57 ± 0.15 de |
| ZY-6 | 2.23 ± 0.24 jk | ZY-23 | 4.87 ± 0.25 cd |
| ZY-19 | 2.30 ± 0.20 jk | ZY-10 | 5.05 ± 0.23 bc |
| ZY-32 | 2.50 ± 0.10 ij | ZY-30 | 5.27 ± 0.21 ab |
| ZY-13 | 2.68 ± 0.13 i | ZY-7 | 5.50 ± 0.24 a |
| PSB Incidence (%) | PSB Severity (%) | Relative PSB Control (%) | |
|---|---|---|---|
| CK | |||
| YB | |||
| SR | 93.33 ± 2.89 a | 65.85 ± 1.16 a | |
| SR + YB | 11.67 ± 2.89 b | 6.79 ± 0.95 b | 89.65 ± 0.81 |
| SR + oxadiazol | 13.33 ± 2.89 b | 6.75 ± 0.99 b | 89.79 ± 0.13 |
| Root Length (cm) | Plant Height (cm) | Root Fresh Weight (g) | Total Fresh Weight (g) | |
|---|---|---|---|---|
| CK | 11.04 ± 1.62 a | 14.00 ± 1.80 c | 1.06 ± 0.45 a | 2.92 ± 0.69 b |
| YB | 11.99 ± 3.11 a | 16.33 ± 1.64 a | 1.41 ± 0.69 a | 3.69 ± 0.61 a |
| SR | 10.64 ± 1.70 a | 6.71 ± 1.80 d | 0.39 ± 0.22 b | 1.14 ± 0.41 c |
| SR + YB | 11.57 ± 1.40 a | 15.18 ± 1.73 b | 1.20 ± 0.58 a | 3.61 ± 0.87 a |
| SR + oxadiazol | 11.36 ± 2.47 a | 16.26 ± 1.61 a | 1.10 ± 0.43 a | 3.16 ± 0.19 b |
| CAT (U/g) | SOD (U/g) | POD (U/g) | LOX (U/g) | MDA (nmol/g) | |
|---|---|---|---|---|---|
| CK | 136.629 ± 11.019 c | 18.026 ± 1.286 d | 8659.460 ± 581.372 c | 7480.759 ± 1918.007 bc | 48.146 ± 3.495 c |
| YB | 225.28 ± 10.826 b | 35.333 ± 1.513 b | 13,505.147 ± 556.389 b | 963.902 ± 126.205 d | 43.715 ± 4.689 c |
| SR | 182.104 ± 33.304 b | 22.628 ± 2.145 cd | 12,580.234 ± 1473.519 b | 10,158.530 ± 1390.438 b | 86.930 ± 3.738 a |
| SR + YB | 369.412 ± 81.563 a | 43.747 ± 3.713 a | 16,285.935 ± 1045.415 a | 13,688.035 ± 1020.885 a | 64.083 ± 2.550 b |
| SR + oxadiazol | 307.315 ± 33.457 a | 28.257 ± 5.170 c | 14,786.548 ± 1877.844 ab | 5136.207 ± 631.574 c | 64.252 ± 3.435 b |
Disclaimer/Publisher’s Note: The statements, opinions and data contained in all publications are solely those of the individual author(s) and contributor(s) and not of MDPI and/or the editor(s). MDPI and/or the editor(s) disclaim responsibility for any injury to people or property resulting from any ideas, methods, instructions or products referred to in the content. |
© 2025 by the authors. Licensee MDPI, Basel, Switzerland. This article is an open access article distributed under the terms and conditions of the Creative Commons Attribution (CC BY) license (https://creativecommons.org/licenses/by/4.0/).
Share and Cite
Chang, Y.; Dong, Q.; Zhang, L.; Goodwin, P.H.; Xu, W.; Xia, M.; Zhang, J.; Sun, R.; Wu, C.; Wu, K.; et al. Peanut Growth Promotion and Biocontrol of Blight by Sclerotium rolfsii with Rhizosphere Bacterium, Bacillus siamensis YB-1632. Agronomy 2025, 15, 568. https://doi.org/10.3390/agronomy15030568
Chang Y, Dong Q, Zhang L, Goodwin PH, Xu W, Xia M, Zhang J, Sun R, Wu C, Wu K, et al. Peanut Growth Promotion and Biocontrol of Blight by Sclerotium rolfsii with Rhizosphere Bacterium, Bacillus siamensis YB-1632. Agronomy. 2025; 15(3):568. https://doi.org/10.3390/agronomy15030568
Chicago/Turabian StyleChang, Yinghang, Qianqian Dong, Limei Zhang, Paul H. Goodwin, Wen Xu, Mingcong Xia, Jie Zhang, Runhong Sun, Chao Wu, Kun Wu, and et al. 2025. "Peanut Growth Promotion and Biocontrol of Blight by Sclerotium rolfsii with Rhizosphere Bacterium, Bacillus siamensis YB-1632" Agronomy 15, no. 3: 568. https://doi.org/10.3390/agronomy15030568
APA StyleChang, Y., Dong, Q., Zhang, L., Goodwin, P. H., Xu, W., Xia, M., Zhang, J., Sun, R., Wu, C., Wu, K., Xu, S., & Yang, L. (2025). Peanut Growth Promotion and Biocontrol of Blight by Sclerotium rolfsii with Rhizosphere Bacterium, Bacillus siamensis YB-1632. Agronomy, 15(3), 568. https://doi.org/10.3390/agronomy15030568
